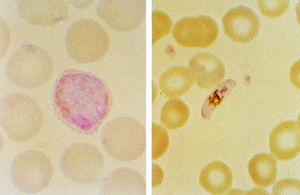

El paludismo o malaria es una enfermedad producida por protozoos intracelulares y transmitida por la picadura del mosquito Anopheles. Es la enfermedad parasitaria más importante del ser humano, ya que cada año se producen más de 300 millones de nuevos casos y más de un millón de muertes. Esta enfermedad ha sido erradicada de Norteamérica y Europa, pero ha permanecido en diversas zonas tropicales en más de 100 países, en donde 1.600 millones de personas se encuentran expuestas a la infección. Por otra parte, han aparecido múltiples problemas de resistencia farmacológica del parásito y de los vectores frente a los insecticidas. El paludismo constituye un grave problema para los habitantes de los países tropicales y para las personas que viajan a estas zonas1,2.
En el presente trabajo se exponen los aspectos más importantes de esta enfermedad, especialmente los de tipo epidemiológico y clínico, con especial referencia a la infancia.
El parásito y su ciclo
El paludismo está producido por un grupo de parásitos del género Plasmodium. Los plasmodios son protozoos pertenecientes a la clase Sporozoa y al orden Eucoccidiida, suborden Haemosporidiida. Son necesarios dos hospedadores sucesivos para que se complete el ciclo vital: un hospedador intermediario, el hombre, en el que se realiza la división asexual o esquizogónica del parásito, y un hospedador definitivo, mosquito del género Anopheles, donde se efectúa la multiplicación sexual o esporogónica.
Los distintos estadios del parásito van a ir surgiendo dentro de estos dos hospedadores, por lo que el parásito va a demostrar una gran variabilidad, ello le va a permitir eludir la respuesta inmune. De más de 100 especies de plasmodios existentes, solamente hay cuatro causantes de paludismo en los seres humanos: Plasmodium falciparum, P. vivax, P. ovale, y P. malariae. De todas ellas, P. falciparum es la especie que más casos de paludismo produce en todo el mundo.
En las glándulas salivales de la hembra del mosquito Anofeles infectada se encuentran los esporozoitos, forma infectiva del plasmodio, que pasan al torrente circulatorio con la picadura; gracias a su movilidad alcanzan el hígado en pocos minutos comenzando aquí la fase hepática o esquizogonia hepática. Dentro de los hepatocitos tiene lugar la división asexual de los parásitos, cuyas formas se denominan merozoitos en las multiplicaciones esquizogónicas y, su agrupamiento, esquizonte. Los hepatocitos se rompen cuando los esquizontes han alcanzado su madurez, con lo que los merozoitos pasan a la circulación general donde comienza la denominada fase hemática o esquizogonia hemática.
Los merozoitos penetran en los glóbulos rojos del hospedador intermediario (hombre), y desarrollan en su interior una forma anillada denominada trofozoito. Éste madura en su interior y comienza a dividir su cromatina de manera asexuada, creando en este caso un esquizonte, formado por un número de merozoitos hemáticos predeterminado para cada especie. Una vez maduro, el esquizonte se rompe, liberando los merozoitos a la circulación general, donde pueden invadir nuevos eritrocitos y así producir ciclos continuos. Sin embargo, algunos merozoitos están regulados genéticamente para desarrollarse como gametocitos, macrogametocito o gameto femenino y microgametocito o gametocito masculino, a expensas de los cuales se perpetúa el ciclo epidemiológico3 (fig. 1).
Fig. 1. Extensión fina de sangre que presenta un trofozoito en un primer estadio (forma de anillo) de P. vivax (izquierda). Trofozoito ameboide más maduro de P. vivax (derecha). Coloración Giemsa.
A la última fase se le denomina esporogonia o fase sexuada y dura de 10 a 20 días; sucede en el hospedador definitivo, al ingurgitar la hembra del anofeles la sangre parasitada con los gametocitos. Éstos pasan al estómago del mosquito, donde se va a producir un proceso denominado exflagelación, por el que el microgameto se divide en ocho formas capaces cada una de fecundar a otros tantos macrogametocitos. Como resultado del contacto sexual se forma el zigoto que va a dar paso a un ooquineto, móvil, que penetra en el epitelio columnar quedándose en el tejido conectivo que reviste por fuera el estómago, formando los ooquistes. En ellos se produce la reducción nuclear y la división nuclear y citoplásmica dando lugar a esporozoitos haploides. Estos espo rozoitos salen hacia el hemocele y se reparten por todo el mosquito, aunque tienen un especial tropismo por las glándulas salivales trilobuladas, donde quedan preparadas para ser inoculadas con la saliva en una nueva picadura, con lo cual queda cerrado el ciclo (fig. 2).
Fig. 2. Extensión fina de sangre que presenta un gametocito de P. vivax (izquierda) y gametocito en forma de plátano de P. falciparum (derecha). Coloración Giemsa.
Parece ser que los esporozoitos de especies que producen recidivas, como P. vivax y P. ovale, no sólo pueden desarrollar esquizontes en el hígado, sino que desarrollan también otras formas denominadas hipnozoitos, que permanecen latentes en los hepatocitos hasta que en un momento determinado desarrollan una esquizogonia exoeritrocitaria y luego merozoitos que invaden el torrente circulatorio y provocan recaídas clínicas4.
Epidemiología
En las zonas endémicas de paludismo el grado de infección está determinado por el equilibrio entre el vector, el parásito, la población susceptible y las circunstancias ambientales4.
El 90% de todos los casos de paludismo corresponde al continente africano, en donde predomina la especie P. falciparum en gran parte de los casos de infecciones adquiridas. En Asia y en América Latina existe un ligero predominio de P. vivax. y éste es prácticamente el único en las infecciones adquiridas en América Central. En otras zonas del planeta las infecciones se han incrementado de manera considerable debido a las desforestaciones, los trabajos de minería y agrícolas, y también a la aparición de quimiorresistencias. Entre éstas destacan Tailandia, la República de Myanmar y el Estado de Rondonia en Brasil. La transmisión transplacentaria, aunque rara, es también posible, así como a través de transfusiones o por el uso de agujas contaminadas5.
En Europa el principal paludismo es el importado, es decir, el que se ha adquirido en países en donde es endémico, generalmente en países intertropicales. El aumento progresivo de la enfermedad en estas zonas ha posibilitado un aumento del paludismo en Europa6. En nuestro país se registraron 25 casos de malaria en 1975, cifras que se han incrementado hasta 1998 en que han aparecido 365 casos, debido al turismo (40%) y a la emigración (60%). Se cree, no obstante, que existe una subdeclaración de esta enfermedad7.
La mortalidad de las infecciones causadas por P. falciparum importado a Europa durante los años ochenta se sitúa entre el 2 y el 6%. En España esta mortalidad supone un 3,9%.
Patogenia
Las principales alteraciones orgánicas se derivan de la acción patógena de la infección en el interior de los vasos capilares. El proceso es el siguiente: los hematíes parasitados son más frágiles, su contenido en oxígeno disminuye y tienen tendencia a adherirse a receptores específicos del endotelio capilar. Entre ellos se ha identificado el CD36, que se correlaciona con formaciones en roseta de hematíes parasitados, y el ICAM-1 (intracellular adherent molecule) en la pared endotelial.
Los mecanismos de citoadherencia en el territorio capilar cerebral son más frecuentes que en otras áreas y se correlacionan con el valor del factor de necrosis tumoral (TNF); éste se considera como un mediador de esta citoadherencia y suele elevarse en las infecciones graves. El TNF interfiere en la gluconeogénesis y es responsable de la hipoglucemia que se registra en los casos de paludismo grave. Los hematíes parasitados emiten unas protuberancias que los llevan a agruparse formando unas masas eritrocitarias grumosas, lo cual, unido a los fenómenos anteriores, determina un enlentecimiento de la circulación capilar que conduce a la anoxia tisular en diversos órganos. Este fenómeno ocurre con más frecuencia en las parasitaciones por P. falciparum debido a su mayor virulencia y su mayor capacidad de penetración eritrocitaria.
Lesiones producidas
El sistema nervioso central está afectado en el paludismo cerebral, producido por P. falciparum. Los capilares meníngeos y de la sustancia gris cerebral presentan apelotonamiento de hematíes parasitados. En la corteza cerebal son más clásicas las oclusiones capilares como hemorragias «en anillo», centradas por un vaso, pero sin infiltrado inflamatorio.
El bazo aumenta de tamaño y presenta dilatación de los senos, con hiperplasia celular y abundantes gránulos de pigmento malárico (hemozoina) en sus macrófagos; en la infección crónica se produce fibrosis. El hígado presenta hipertrofia e hiperplasia de las células de Kupffer, que contienen pigmento malárico de color marrón negruzco.
En el riñón aparece un punteado hemorrágico en la corteza y en la médula. En el síndrome nefrótico asociado a P. malarie se observa un engrosamiento de la membrana basal de los capilares glomerulares, debido al depósito de complejos específicos de antígeno-anticuerpo que pueden ser identificados por inmunofluorescencia (glomerulonefritis membranosa). La placenta suele ser uno de los órganos más afectados; en los espacios intervellosos suelen observarse depósitos de hemozoina entre masas de fibrina, así como numerosos esquizontes maduros.
Estado inmunitario
Los plasmodios provocan dos tipos de respuesta inmunitaria si el paciente no muere: la eliminación de los mismos de la circulación y las vísceras, acompañado de una restitución de la lesión causada y una reducción progresiva de la parasitemia tras la fase aguda que produce escasa sintomatología.
La mayoría de los habitantes del oeste de África presenta una inmunidad natural hacia P. vivax. En estas áreas, menos de un 20% de la población posee el antígeno Duffy (FyaFyb) determinante del grupo sanguíneo. P. vivax necesita este antígeno en la superficie eritrocitaria para facilitar su penetración. También la hemoglobina S confiere cierta protección contra P. falciparum. En condiciones aerobias la presencia de hemoglobina S retrasa ligeramente el crecimiento parasitario, fenómeno que se ve muy incrementado ante situaciones bajas de oxígeno. También se ha demostrado que el déficit de glucosa-6-fosfato-deshidrogenasa produce cierto grado de protección, en algunos casos, especialmente en mujeres.
La inmunidad natural está demostrada en el período neonatal, transferida por la madre desde el período prenatal. Esta inmunidad es transitoria y puede prolongarse hasta el año de vida, tras el cual el niño ya puede presentar parasitemias elevadas, lo cual puede explicar la gran mortalidad en niños de 1 a 5 años de edad. La inmunidad parcial homóloga que se va desarrollando es específica de especie y también de cepa, sin existir inmunidad cruzada entre especies.
Los niños son, precisamente, el grupo de edad más sensible frente a la malaria cerebral mortal; también lo son las primigrávidas, los inmigrantes de una zona no endémica a una región endémica, en cuyo grupo pueden incluirse los turistas europeos. En embarazos sucesivos la función esplénica se va restituyendo y la posible infección se acompaña de un menor número de complicaciones.
Manifestaciones clínicas
Inicialmente los síntomas del paludismo son inespecíficos y aparecen tras un período de incubación de 8-30 días, o incluso de un año en casos producidos por cepas de P. vivax. Son frecuentes la sensación de malestar, cefalea, cansancio, molestias abdominales, mialgias y fiebre y pueden sugerir cualquier otra enfermedad. La cefalea, aunque puede ser intensa, no se acompaña nunca de rigidez de nuca ni de fotofobia; las mialgias no suelen ser tan intensas como en el dengue, la leptospirosis o el tifus.
Son frecuentes las náuseas, los vómitos y la hipotensión ortostática, así como los clásicos paroxismos palúdicos, de varias horas de duración, consistentes en picos febriles precedidos de escalofríos. La fiebre es anárquica e irregular en las fases iniciales en los casos de P. falciparum, superando incluso los 40 ºC en personas no inmunes y en niños y se acompaña de taquicardia e incluso delirium. Al final de la crisis febril aparece sudación abundante y somnolencia. En el paludismo por P. vivax aparece una periodicidad paroxística febril terciaria. Pueden aparecer convulsiones febriles en niños, generalmente por P. falciparun, lo cual sugiere una afección cerebral8-11.
La esplenomegalia es uno de los signos clínicos más frecuentes en las personas parasitadas, aunque con frecuencia tarda varios días en palparse. En niños pequeños también es frecuente la aparición de hepatomegalia, que es más intensa cuanto menor es la edad. La ictericia aparece en algunos casos, no suele ser intensa, desaparece al cabo de 1-3 semanas y se debe a P. falciparum. Es importante reseñar que el paludismo no se acompaña de ningún tipo de erupción cutánea como en otras entidades, como la septicemia meningocócica, el tifus, la fiebre entérica, los exantemas virales, las reacciones a fármacos o la leptospirosis. En la tabla 1 se detallan algunas de las características de la infección producida por distintos tipos de plasmodios3.
Manifestaciones graves producidas por P. falciparum
Paludismo cerebral
La meningoencefalitis y el coma son manifestaciones típicas de este tipo de paludismo, que se acompaña de una tasa de mortalidad del 20% en adultos y del 15% en niños, aproximadamente. El inicio del cuadro puede ser gradual o súbito tras una convulsión. También pueden aparecer obnubilación y alteraciones de la conducta12.
El cuadro se manifiesta como una encefalopatía simétrica difusa y son infrecuentes los signos neurológicos focales. No se observan signos de irritación meníngea y la respuesta de los reflejos y del tono muscular son variables. En niños pequeños es frecuente la anemia y en ellos aparecen convulsiones generalizadas y repetidas. Alrededor del 10% de los niños que sobreviven al paludismo cerebral presentan algún déficit neurológico residual, especialmente aquellos que han presentado hipoglucemia, anemia grave, convulsiones repetidas y coma profundo.
Hipoglucemia
Es una complicación muy importante y frecuente del paludismo grave y se asocia a un pronóstico desfavorable, particularmente en niños y mujeres embarazadas. La hipoglucemia se debe a la insuficiencia de la gluconeogénesis hepática y al incremento en el consumo de glucosa por el huésped y el parásito. La situación se complica todavía más porque la quinina y la quinidina, empleadas en casos de paludismo grave, resistente a la cloroquina, son potentes estimuladores de la secreción de insulina pancreática. El diagnóstico clínico de la hipoglucemia es difícil ya que no suelen aparecer los signos físicos habituales de sudación, taquicardia, piel de gallina, etc., y los trastornos neurológicos que aparecen no pueden diferenciarse de los causados por el palu-
dismo.
Insuficiencia renal
Las alteraciones renales son más frecuentes en los adultos que en los niños con paludismo grave por P. falciparum. Parece ser que el cuadro se debe a que el secuestro de eritrocitos parasitados interfiere en el flujo renal de la microcirculación. El cuadro clínico se parece al de la necrosis tubular aguda y en los pacientes que sobreviven el flujo de orina aparece a los 4 días, aproximadamente, y los valores séricos de creatinina se normalizan tras un período medio de 17 días. La diálisis aumenta considerablemente las posibiliades de supervivencia de los pacientes.
Alteraciones hematológicas
La anemia se debe a la destrucción acelerada de eritrocitos y a una eritropoyesis poco eficiente. Con frecuencia, la intensidad de la anemia requiere transfusión, especialmente en el paludismo grave de personas no inmunes y en niños con anemia grave debido a infecciones palúdicas repetidas. Éstas son consecuencia, frecuentemente, de infecciones reiteradas tratadas con cloroquina u otros fármacos, a los cuales los parásitos se han hecho resistentes.
En ocasiones, pueden aparecer alteraciones leves de la coagulación y trombocitopenia. Las hemorragias graves con signos de coagulación intravascular diseminada se observan en menos del 5% de los pacientes con paludismo cerebral.
Acidosis láctica
Esta alteración acompaña a la hipoglucemia habitualmente. Los eritrocitos infectados y secuestrados interfieren el flujo de la microcirculación y se produce una glucólisis anaerobia; la producción de lactato por los parásitos se combina con la insuficiente eliminación del lactato hepático, lo que se traduce en una acidosis láctica. La respiración acidótica, que representa un signo de mal pronóstico en el paludismo grave, se suele complicar con insuficiencia circulatoria refractaria a la expansión de volumen y al tratamiento con fármacos inotrópicos, o con parada respiratoria.
Edema pulmonar no cardiogénico
La patogenia de esta complicación no está aclarada y la presentan exclusivamente los adultos con paludismo grave por P. falciparum, y representa una mortalidad mayor del 80%.
Otras complicaciones
En casos de paludismo cerebral puede aparecer neumonía por aspiración en el curso de las convulsiones y provocar la muerte. También se ha observado mayor incidencia de infecciones sobreañadidas, debidas posiblemente a las alteraciones inmunitarias o al empleo de catéteres en el curso del tratamiento y monitorización del paciente.
Paludismo en situaciones especiales
Durante el embarazo, la infección por P. falciparum puede producir la muerte fetal. En primíparas y secundíparas de las zonas endémicas, el paludismo se asocia con bajo peso al nacimiento. En las embarazadas de las zonas con transmisión inestable de paludismo, la infección puede producir parasitemia intensa con anemia, hipoglucemia y edema pulmonar agudo. Las complicaciones más frecuentes son el sufrimiento fetal, la prematuridad, el aborto y el peso bajo al nacer. El paludismo congénito se observa en menos del 5% de recién nacidos de madres infectadas y está en relación directa con la densidad parasitaria en la sangre materna y la placenta. La clínica en estos casos se caracteriza por la presencia de fiebre, ictericia, cianosis, esplenomegalia, alteraciones digestivas y convulsiones13-20.
En niños es especialmente importante la infección por P. falciparum. La mayoría de las personas que fallecen anualmente son niños africanos. En los casos de niños con paludismo grave son frecuentes las siguientes alteraciones: convulsiones, coma, hipoglucemia, acidosis metabólica y anemia grave. Son más raras la ictericia, la insuficiencia renal aguda y el edema pulmonar agudo. Generalmente, los niños responden muy bien a los fármacos antipalúdicos21-23.
El paludismo también puede transmitirse por transfusión de sangre, pinchazos de aguja y empleo compartido de agujas infectadas por drogadictos. En estos casos el período de incubación es breve, debido a que no se produce una fase preeritrocitaria de desarrollo; la enfermedad y el tratamiento son similares a los de la infección adquirida de forma natural, aunque aquella es especialmente grave en los drogadictos.
Complicaciones
Algunos pacientes que residen en zonas de paludismo endémico de África y Asia presentan una respuesta inmunitaria alterada a las infecciones repetidas, que se caracteriza por esplenomegalia masiva, hepatomegalia, elevación de la IgM, presencia de anticuerpos palúdicos y linfocitosis B. A este cuadro se le ha denominado «esplenomegalia palúdica hiperreactiva» y cursa, además, con anemia, pancitopenia y dolor abdominal. Los enfermos tienen tendencia a padecer infecciones de repetición y sepsis y, a veces, pueden evolucionar a trastornos malignos.
También puede aparecer, en pacientes infectados por P. malariae, lesión del glomérulo renal por inmunocomplejos solubles y producción de una nefropatía palúdica, causa de un síndrome nefrótico. En estos casos la respuesta al tratamiento es escasa, tanto a los antipalúdicos, como a los corticoides y citotóxicos.
Por otra parte, se cree que puede existir una relación entre el paludismo y el linfoma de Burkitt y la infección por el virus de Epstein-Barr. Es posible que la inmunosupresión que produce la infección palúdica provoque la infección por virus linfomatosos. Se ha observado que la prevalencia del linfoma de Burkitt es muy elevada en la infancia en las zonas palúdicas de África.
Diagnóstico
El diagnóstico se sustenta en métodos directos mediante la demostración del parásito y en métodos indirectos basados en datos de laboratorio. La demostración del parásito se realiza con la identificación de las formas asexuales del plasmodio en los frotis de sangre periférica, teñidas con las técnicas de Giemsa o Romanosky, entre otras. Los frotis a estudiar son finos o gruesos.
Los frotis finos se deben secar rápidamente al aire, se fijan y se tiñen. El grado de parasitemia se expresa como el número de eritrocitos parasitados en 1.000 células. La relación entre parasitemia y pronóstico es compleja ya que también interviene en la misma el estado inmunitario del paciente. En el paludismo grave, los casos de peor pronóstico son aquellos en los que predominan las formas más maduras de P. falciparum, es decir, más del 20% de parásitos con pigmento visible o los esquizontes circulantes en la sangre periférica, y también en aquellos en los que se observa pigmento palúdico fagocitado en más del 5% de los neutrófilos.
Los frotis gruesos se secan y se tiñen. Este frotis concentra los parásitos de 20 a 40 veces en comparación con el frotis fino, por lo que incrementa la sensibilidad diagnóstica. Se calcula el número de parásitos y leucocitos por unidad de volumen y se examinan de 100 a 200 campos. El pigmento palúdico se observa en el interior de los monocitos o en los leucocitos polimorfonucleares. Tras la eliminación de los parásitos el pigmento es evidente en los fagocitos de sangre periférica, en los aspirados de médula ósea y en otros materiales obtenidos para estudio. Esta técnica permite determinar la positividad o negatividad malárica pero no la especie; no obstante, sigue siendo el método de elección para el diagnóstico.
Otro método directo es la detección del ADN del parásito mediante reacción en cadena de la polimerasa (PCR) y empleo de sondas. Es un método muy sensible. Recientemente, se ha introducido otra prueba diagnóstica simple, sensible y específica que permite detectar la proteína 2 rica en histidina de P. falciparum en muestras de sangre obtenidas mediante un pinchazo en el dedo24,25. En casos de parasitaciones bajas o en estudios epidemiológicos pueden emplearse técnicas serológicas de inmunofluorescencia y ELISA, entre otras.
Los datos de laboratorio más significativos son la anemia normocrómica y normocítica. Es frecuente la aparición de leucopenia y plaquetopenia; la velocidad de sedimentación y la proteína C están elevadas. En el paludismo grave existe acidosis metabólica con disminución de las concentraciones plasmáticas de glucosa, sodio, bicarbonato, calcio, fosfato y albúmina y elevaciones de lactato, nitrógeno ureico, creatinina, enzimas musculares y hepáticas y bilirrubina conjugada y no conjugada. También existe hipergammaglobulinemia y la orina suele ser normal. En los pacientes con paludismo cerebral el líquido cefalorraquídeo es normal o presenta valores ligeramente elevados de proteínas totales.
Tratamiento
El tratamiento de esta enfermedad es complejo, debido, sobre todo, a la cantidad de resistencias farmacológicas que aparecen en diversas partes del mundo, especialmente en Asia26.
Paludismo no complicado
Las infecciones producidas por P. vivax, P. malariae y P. ovale, así como las cepas sensibles de P. falciparum, deben ser tratadas con fosfato de cloroquina por vía oral a 10 mg base/kg inicialmente, más 5 mg/kg 6 h después durante el primer día; el segundo, tercero, cuarto y quinto días se administran 5 mg/kg. La dosis total será de 35 mg/kg en 5 días, para un adulto. Los efectos secundarios pueden ser náuseas, vómitos, cefaleas, visión borrosa, hipotensión y prurito.
Si el paciente presenta malaria por P. falciparum y procede de un área resistente a la cloroquina, se tratará con sulfato de quinina oral, a dosis de 10 mg/kg cada 8 h, durante 7-10 días. Este preparado por vía oral es muy amargo y produce hipoglucemia, tinnitus, sordera, náuseas, vómitos y disforia. También pueden aparecer otras reacciones adversas como, por ejemplo, alteraciones neuropsiquiátricas, digestivas e hipotensión.
Si no se dispone de quinina y el enfermo tolera la vía oral se le puede administrar mefloquina, 750 mg en dosis de inducción, seguida de 500 mg a las 8 h y, finalmente, 250 mg a las 24 h. En niños de más de 15 kg de peso la dosis es de 25 mg/kg en dos tomas. En la actualidad, este preparado se utiliza, preferentemente, como profiláctico. Puede producir náuseas, diarrea, hipotensión, bradicardia y dolor abdominal27.
Otro esquema de tratamiento que puede utilizarse, en casos de resistencia a la cloroquina, es el empleo de sulfadoxina-pirimetamina en toma única de tres comprimidos en el adulto y medio comprimido por cada 10 kg de peso en niños. Este preparado no debe ser empleado en embarazadas ni en recién nacidos.
Para el tratamiento es necesaria la hospitalización de las mujeres embarazadas, los niños pequeños, los pacientes que no pueden tomar tratamiento por vía oral y las personas no inmunes, por ejemplo los viajeros, en los que se sospecha paludismo. Cuando no se conoce con exactitud la especie de paludismo, el tratamiento debe ser el indicado para P. falciparum. La negatividad del frotis sanguíneo no excluye el paludismo; en este caso, es necesario examinar frotis grueso de sangre cada 1 o 2 días para excluir el diagnóstico. Si el grado de parasitemia no disminuye por debajo del 25% del valor inicial a las 48 h, o si no ha desaparecido la parasitemia al cabo de 7 días, habiendo llevado el tratamiento correctamente, es posible que exista resistencia farmacológica, por lo que se debe modificar el régimen terapéutico.
Paludismo grave
Si el paciente es sensible a la cloroquina se administrará este fármaco a 5 mg/kg en solución isotónica intravenoso durante 6 h. Posteriormente, se sigue la misma pauta hasta completar una dosis total de 25 mg/kg. También puede administrarse por vía intramuscular o subcutánea a dosis de 3,5 mg/kg28.
Si el paciente es resistente a la cloroquina se emplea el diclorhidrato de quinina intravenoso a dosis de 10 mg/kg en perfusión lenta de 500 ml durante 4 h, que se repite cada 8-12 h, hasta completar 7 días de tratamiento. En algunas zonas se emplean fármacos chinos derivados de la artemisina, esquizonticidas que pueden aplicarse mediante supositorios, con buenos resultados y, al parecer, inocuos29. El paludismo grave por P. falciparum es una urgencia médica que requiere atención intensiva y tratamiento muy cuidadoso.
En ocasiones, puede estar indicada la exanguinotransfusión en pacientes con parasitemia intensa (más del 15%) y disfunción de órganos vitales. En casos de pacientes en coma, se les administrará fenobarbital una sola dosis (5 a 20 mg/kg) para prevenir las convulsiones.
Todos los pacientes tratados con quinina y quinidina intravenosa deberán recibir infusión de dextrosa al 5-10% y medir la glucosa y el hematócrito cada 6 h; también se debe controlar la función renal y el equilibrio hídrico periódicamente.
Investigaciones recientes han demostrado la validez y la buena tolerancia de nuevas moléculas en seres humanos, como la fosmidomicina y su molécula derivada (FR-900098). Ambas moléculas son capaces de inhibir la actividad de ciertas enzimas del parásito y son capaces de actuar contra parásitos multirresistentes tanto in vitro como in vivo30. Asimismo, avances en el conocimiento de la interferencia en la formación de pigmento de la malaria pueden aportar nuevos fármacos basados en las quinolonas31.
Prevención
La enfermedad debe ser controlada mediante la utilización de insecticidas para eliminar el mosquito, el diagnóstico rápido y el tratamiento adecuado del paciente y la administración de quimioprofilaxis a grupos de alto riesgo.
Para prevenir las picaduras es conveniente evitar la exposición durante las horas en las que suele picar el mosquito, desde el atardecer al amanecer, llevar ropa que cubra la piel y utilizar repelentes de insectos y redecillas impregnadas de insecticida. La utilización de redes para las camas, sobre todo las impregnadas con permetrina, reducen la incidencia del paludismo.
La quimioprofilaxis depende de diversos factores y nunca es totalmente segura. Todas las mujeres embarazadas de riesgo deben recibir la profilaxis, así como los niños de 3 meses a 4 años de edad en las zonas en que el paludismo causa una elevada mortalidad infantil. Los viajeros deben recibir también la quimioprofilaxis desde al menos 7 días antes de su partida y deberá mantenerla hasta 4 semanas después de que el viajero haya abandonado la zona endémica. El medicamento a aplicar dependerá de la zona que se visite o en que se resida32-34.
La mefloquina es el agente profiláctico antipalúdico de elección en áreas resistentes a la cloroquina. Los Centros para el Control y Prevención de Enfermedades de los EE.UU. recomiendan una dosis semanal de este preparado para todos los viajeros. Entre sus efectos secundarios se encuentran los siguientes: náuseas, mareos, confusión, alteraciones del sueño, disforia y, más raramente, convulsiones y encefalopatía. Este preparado se desaconseja durante el primer trimestre del embarazo, en niños menores de 15 kg, en epilépticos y ante algunas cardiopatías. Su dosis es de 250 mg por semana, máximo 14 semanas (4 mg/kg/semana).
La cloroquina es otro agente eficaz y de elección en zonas endémicas sensibles a este fármaco. Es inocua en el embarazo y tiene escasos efectos secundarios, pero se ha observado resistencia de los plasmodios en África y en otras zonas del mundo. Su dosificación es la siguiente: 5 mg base/kg y semana, como mínimo, hasta una dosis máxima de 300 mg en adultos. En determinadas zonas conviene asociar a la cloroquina el proguanil a dosis de 200 mg/día (3 mg/kg/día)28.
Un alternativa a estos medicamentos es la doxiciclina, no exenta de efectos secundarios en niños, así como la primaquina, eficaz como profilaxis del paludismo por P. ovale y P. vivax.
Desde 1986 existe una vacuna producida sintéticamente que ha demostrado cierta efectividad y que actúa sobre los antígenos del estado sanguíneo del parásito; por ello, no sería efectiva en viajeros a zonas endémicas. Los ensayos de esta vacuna, realizados en África, frente a P. falciparum, han demostrado una protección de más del 30% en niños de 1 a 5 años de edad4,35. Se cree que el estudio y conocimiento de la secuencia genómica del parásito y de nuevos receptores de la placenta pueden lograr vacunas más útiles, dirigidas a varias especies y conseguir nuevas terapéuticas para esta enfermedad36-38.